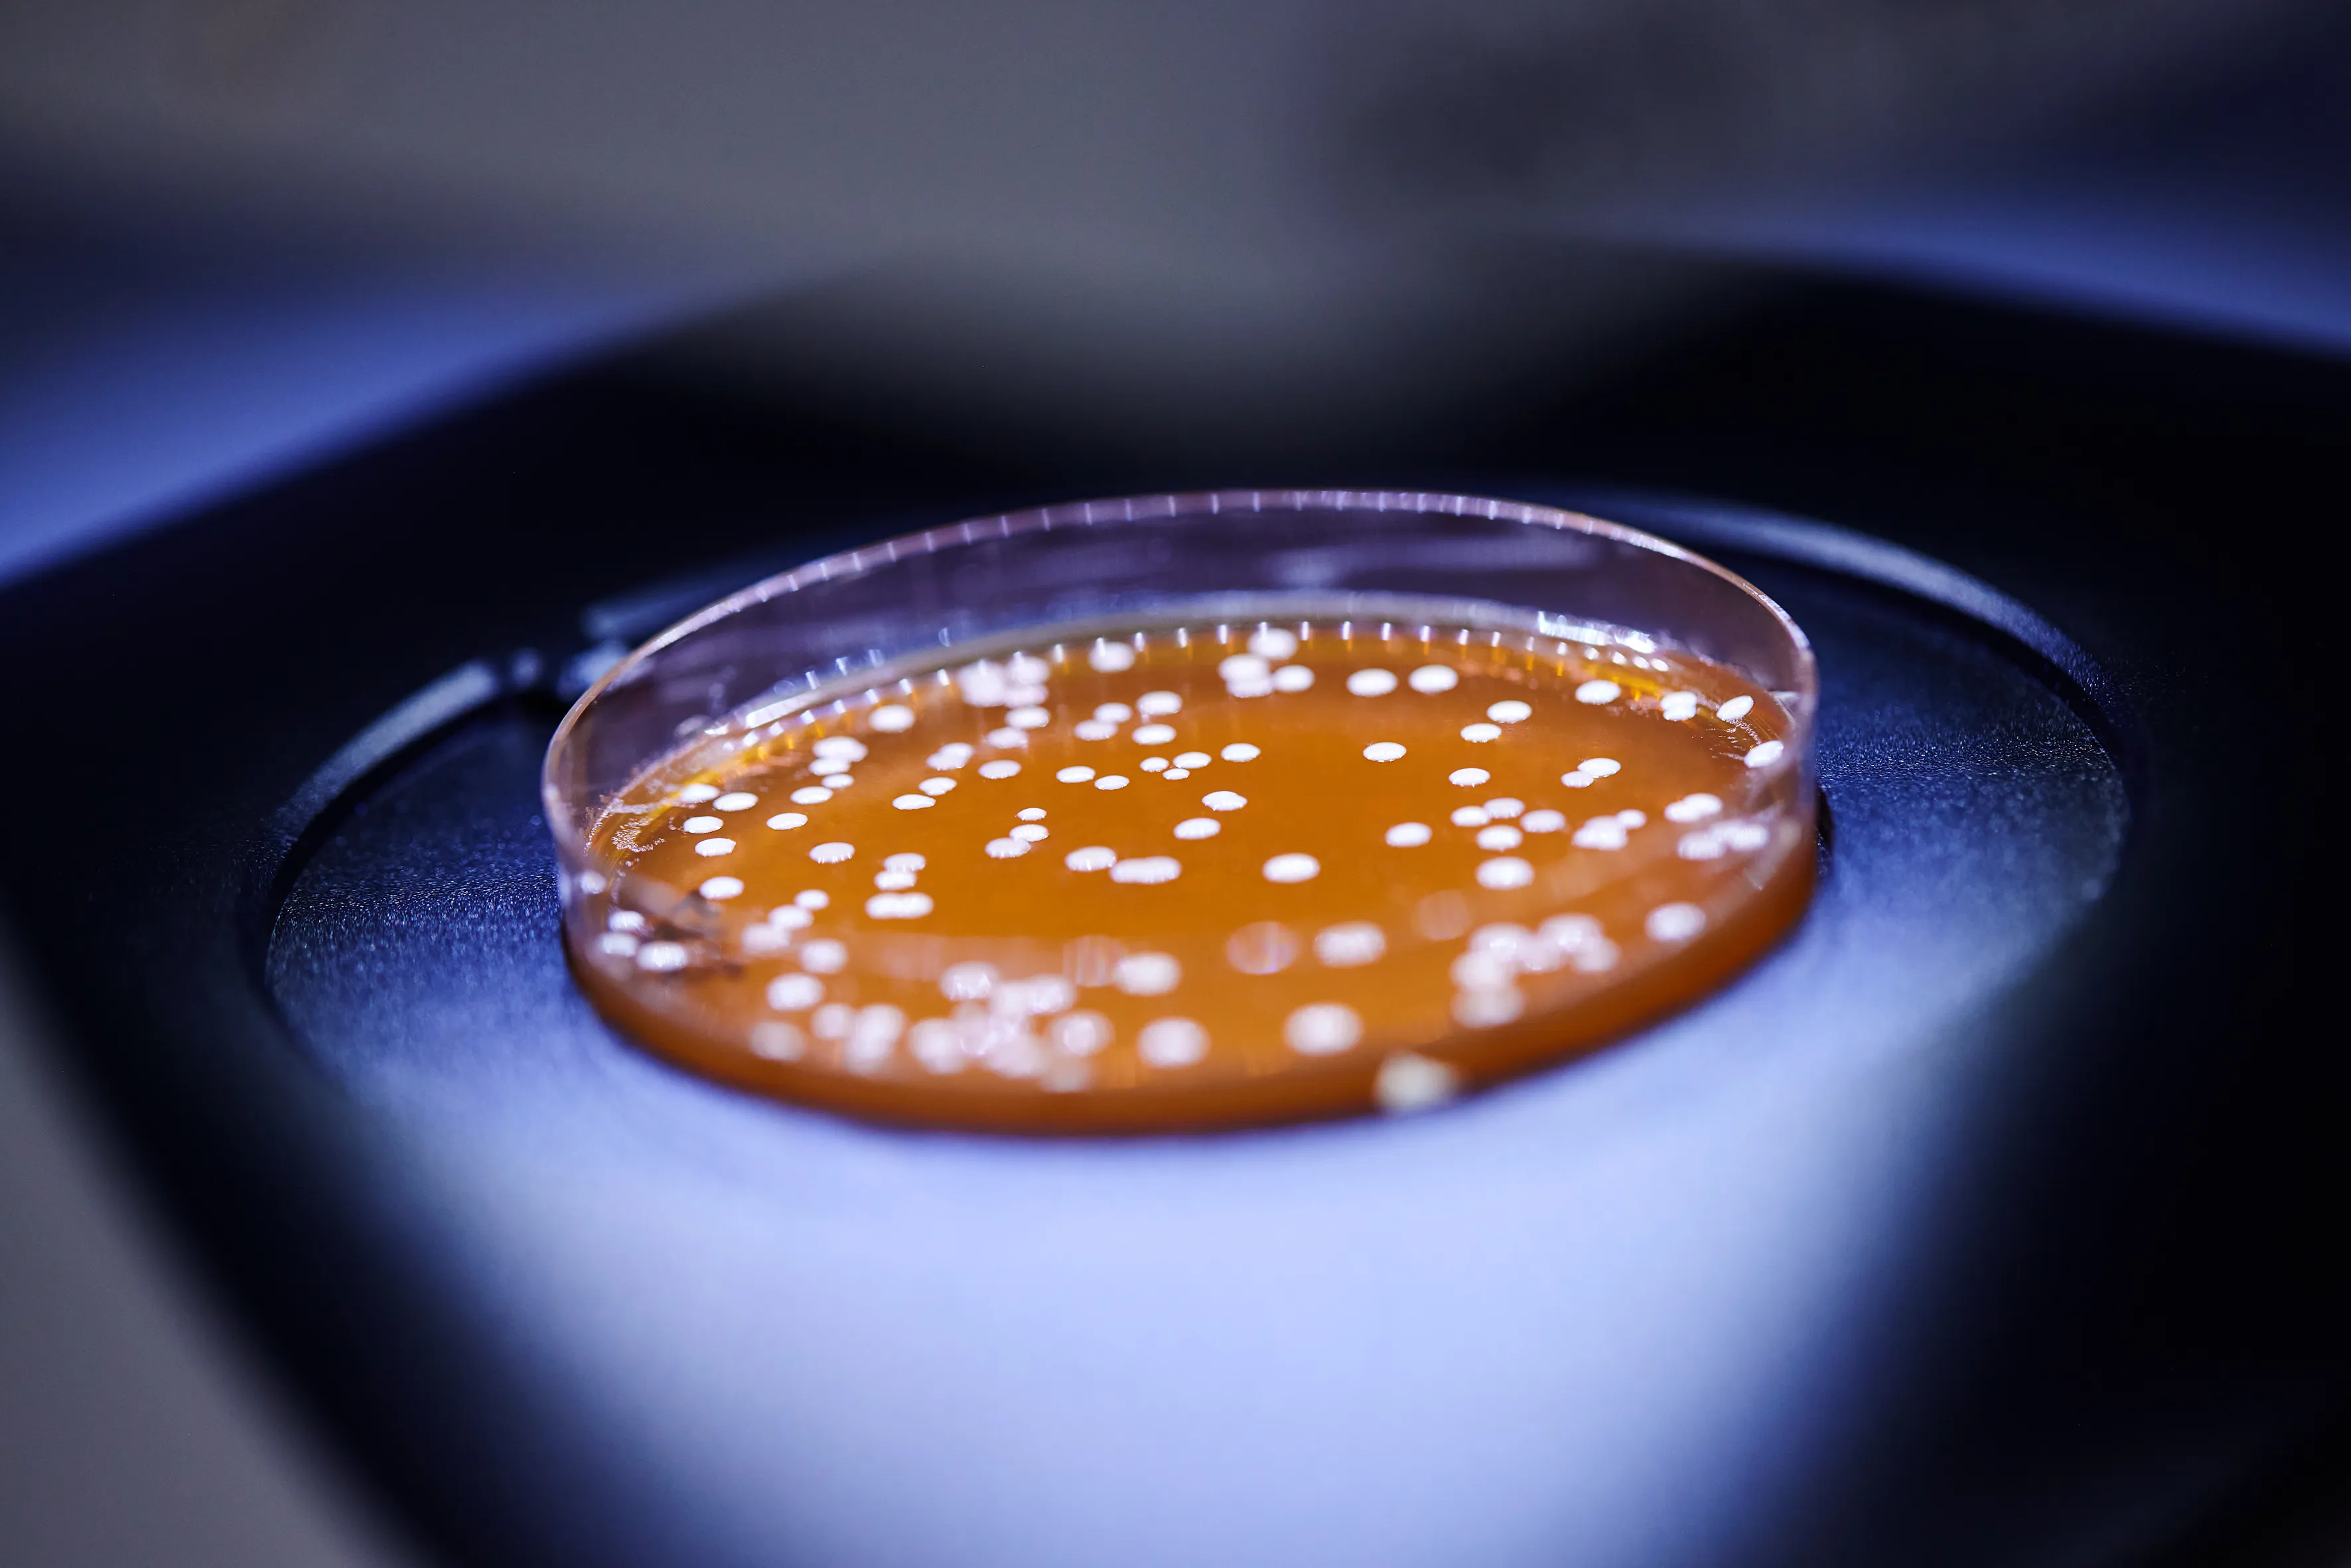
Lab5

Probi, part of Symrise group, joins new Care & Wellness Division. Read more here.
Take the chance to meet our experts and explore the latest solutions for wellness and active living in New Jersey April 14–15!
We offer patented, safe, scientifically documented solutions that are supported by robust, state-of-the-art preclinical and clinical studies. Using validated research methodologies, we can help you develop evidence-based health solutions and proven probiotics.
To date, our scientists and research groups around the globe have published more than 320 peer-reviewed scientific articles and more than 80 clinical trials for the strain LP299V® alone. We also hold more than 350 granted patents and patent applications.
Probi scientists, as well as other research groups, have conducted multiple human clinical trials in the fields of digestive health, iron absorption, immune health, and bone health, among others. A sampling of these studies can be accessed via our digital library.
Learn more
We tirelessly pursue new insights and knowledge, using them to help you create specialized health solutions that offer unique benefits. Our expertise fuels our process, from research to manufacturing, enabling us to shorten our time to market without compromising quality.
Learn more
At Probi® we know that there is always more to learn—about strains we’ve been using for years, as well as undiscovered strains. That’s why we collaborate closely with international partners and academic groups, conducting state-of-the-art preclinical and clinical trials, investigating the underlying mechanisms, and evaluating the health effects of our probiotics.
Learn more

Probi is an innovative, experienced provider of clinically proven biotic strains and solutions. We use our state-of-the-art...
Probi combines innovative R&D, a keen knowledge of the latest trends, and state-of-the-art research to develop proven...